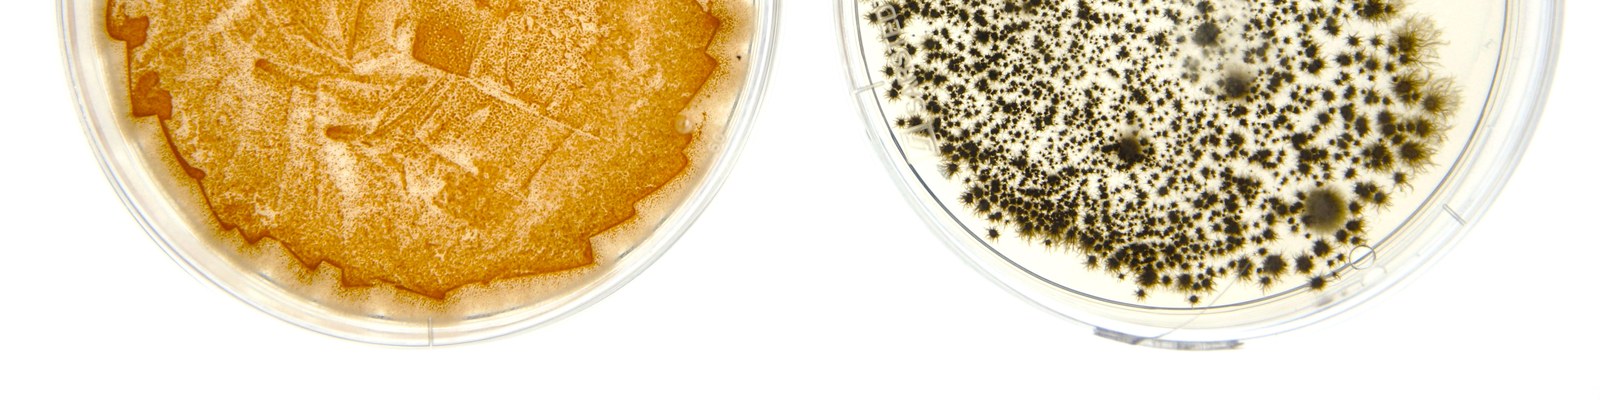

Janzen lab
Microorganisms are a prolific source of structurally diverse and biologically active small molecules, many of which form the basis of clinically important drugs, including antibiotics, anticancer agents, and immunosuppressants. Our research focuses on the discovery and biosynthetic characterization of natural products from Ascomycetes, including widely distributed molds such as Aspergillus species as well as plant pathogens from the genus Colletotrichum.
By uncovering novel natural products, we identify their molecular mechanisms of action and expand the chemical space available for drug discovery, thereby addressing key challenges in pharmaceutical research. Elucidation of their biosynthetic pathways enables the identification of the responsible genes and enzymes, providing a foundation for biosynthetic engineering, production optimization, and the rational design of derivatives with improved biological properties. Beyond pharmaceutical applications, our research contributes to advances in biotechnology and to a deeper understanding of the ecological functions of microbial natural products.